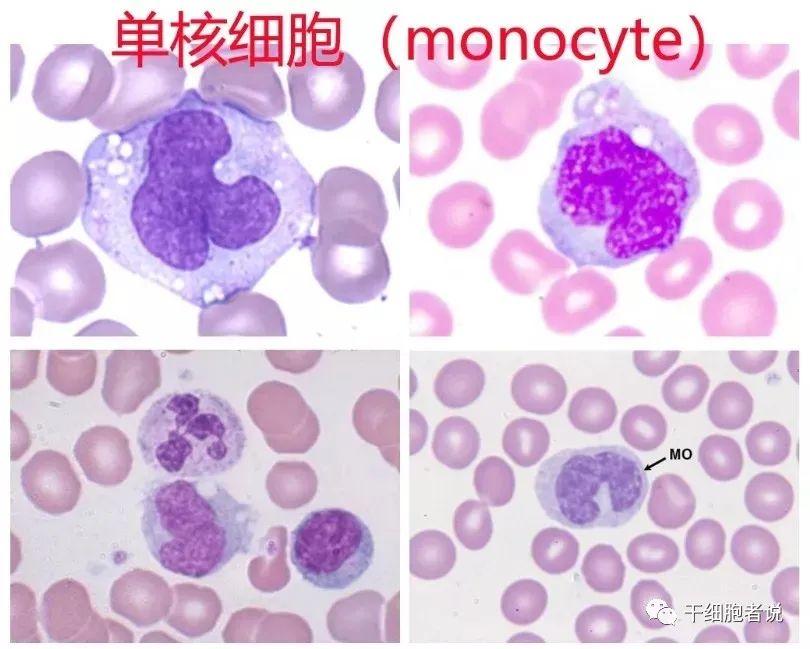
免疫细胞注射价格概览，细胞疗法费用及详细价格表解析

上市公司理财日常,友情与理财的和谐交响曲
上市公司理财日常,探索财富增值与友情的和谐共鸣。公司积极管理资金,寻求最佳理财策略,以实现稳健收益。理财过程中的种种挑战与机遇,成为公司与合作伙伴共同演奏的奇妙交响曲。注重风险控制,灵活调整理财策略,确保资金安全并获...
万名老兵请愿进展更新动态速递
摘要:万名老兵请愿活动迎来最新进展更新。这些老兵通过请愿表达了对国家和社会的高度关注,以及对改善退役军人待遇的强烈愿望。目前,相关部门正在积极处理这些请愿,努力改善退役军人的福利和权益保障。具体进展将在后续公布。这一...
松发股份股票投资全攻略,从入门到进阶指南
松发股份股票投资指南,从入门到进阶。本指南为投资者提供全面的松发股份股票信息,包括公司概况、业绩分析、市场前景等。对于初学者,本指南详细介绍了松发股份的基本情况,如何分析股票走势等基础知识。对于进阶投资者,本指南深入...
新疆旺源驼奶价格表,探寻自信与成就感的源泉
摘要:新疆旺源驼奶价格表是消费者寻求高品质驼奶的参考依据。作为自信与成就感的源泉,旺源驼奶以其卓越的品质和合理的价格,满足不同消费者的需求。价格表提供不同产品系列的定价,让消费者了解并选择适合自己的驼奶产品。旺源驼奶...
日本女忍者电影之旅,自然美景中的心灵探索与宁静之旅
日本女忍者电影不仅展现了精彩的打斗场面,更是一次探索自然美景的旅程。影片中的女忍者角色勇敢坚韧,充满智慧。她们在旅途中寻找内心的平和与宁静,传递出深刻的哲理。电影融合了动作、冒险与自然风光,带领观众领略壮丽的景色,同...
免疫细胞注射价格概览,细胞疗法费用及详细价格表解析
摘要:本文介绍了免疫细胞注射价格表,帮助人们了解免疫细胞疗法及其费用。通过注射免疫细胞,可以增强人体免疫力,预防疾病。不同种类的免疫细胞注射价格不同,具体费用需根据所选项目和医疗机构而定。了解这些信息可以更好地选择适...
龙岩楼市行情速览,自然美景与楼市探索之旅
龙岩楼市行情速览,探索自然美景之旅。关注龙岩房地产市场动态,发现美丽楼盘与自然风光相得益彰。购房者可以体验一场独特的探索之旅,感受自然美景与舒适生活的完美结合。最新楼市信息,尽在掌握,为您的购房决策提供参考。大家好,...
维生素市场行情深度解析,一种观点探讨其发展趋势与前景
摘要:本文深入剖析了维生素行情,详细阐述了一种观点。当前维生素市场受到多种因素的影响,包括供需关系、季节性因素、原材料价格等。通过对这些因素的深入分析,可以更好地理解维生素行情的波动。本文还强调了维生素对人体健康的重...
临汾荣华世家最新动态,小巷中的独特风味探索之旅
临汾荣华世家最新动态:小巷中的独特风味探索之旅。该项目近期推出了一系列新活动,鼓励人们发掘当地小巷中的独特风味和文化魅力。这一动态旨在提升临汾荣华世家的知名度和吸引力,同时推广当地的文化和美食。参与者可以在这些小巷中...
未来已来,科技铸就新篇章,2016辽宁公安演讲比赛高科技装备展示
摘要:在2016年辽宁公安演讲比赛中,高科技装备成为一大亮点。随着未来已来,科技铸就新篇章,此次比赛展示了最新的科技应用,如智能语音识别、数据分析等。这些高科技手段不仅提升了比赛的专业性和观赏性,也展现了公安系统积极...